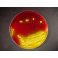
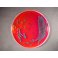
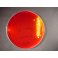

Dealer wanted
Comprehensive Selection of Supplements for Dehydrated Culture Media - New! Specialized Supplements for Optimal Microbiological Media Performance Now available for use with our MicroMedia-branded dehydrated media or as standalone additives – delivering enhanced selectivity, enrichment, and reliability for your lab.
|
Full automatic can lid feeder at Coca-Cola factory - New Unit-Fine Fully Automatic Can Lid Feeder Installed at Coca-Cola Plant |
B20 can lid feeder at Bakalar Brewery -
Unit-Fine Installs First B20 Can Lid Feeder with Round Magazine Loader at Bakalář Brewery
Products
XLD Agar MM0179
Description
Use and description of XLD Agar :
Field : Clinical microbiology, Pharmaceutical microbiology, Food test
Special field : Differentiating media for enteropathogens
Organisms : Salmonella, Shigella
Application :
- Differentiating media for Enterobacteriaceae
- Media for isolation
- Selective Media
Substantial composition : xylose, lysine, desoxycholate
Special field of application :
-
Downloads
Newsletter
In this newsletter publication we highlight our activities, featuring briefly past and upcoming events, new publications, as well as major news!
MicroMedia Trading House
Address: 10130 Tallin Kiriku Tn 6, Hungary
Phone: +36306013634, Fax: ,
Support: support@micromediatradinghouse.com
Address: 10130 Tallin Kiriku Tn 6, Hungary
Phone: +36306013634, Fax: ,
Support: support@micromediatradinghouse.com